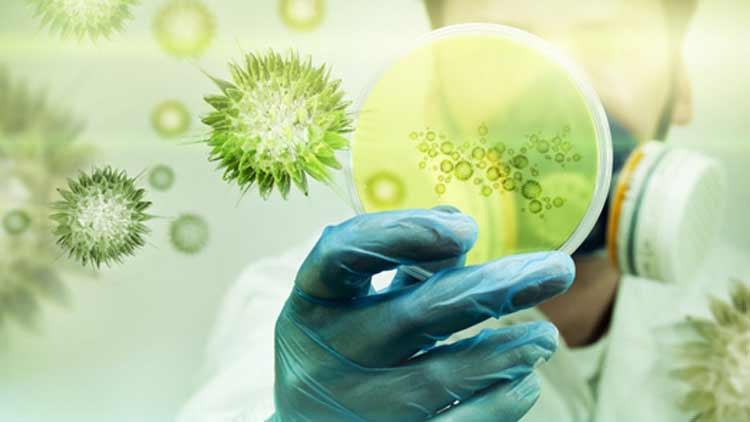

സൂക്ഷ്മതയോടെ കഴിക്കാം; വൈറസിനെ തുരത്താം
text_fieldsകോവിഡ്-19 പടർന്നുപിടിക്കുേമ്പാൾ ലോകം അതീവജാഗ്രതയിലാണ്. ഇൗ രോഗം പ്രധാനമായും പകരുന്നത് അടുത്തിടപഴകുന ്നവർക്കിടയിലാണ്. രോഗിയുടെ ചുമയിലൂടെയോ തുമ്മലിലൂടെയോ തെറിക്കുന്ന ഉമിനീർ കണങ്ങളോ മൂക്കിലെ സ്രവങ്ങളോ ആണ് രോഗം പടരാൻ കാരണമാകുന്നത്. അതുകൊണ്ടാണ് അകലം പാലിക്കാൻ നിർദേശിക്കുന്നത്.
ഭക്ഷണത്തിലൂടെയും ഭക്ഷണപ്പൊതി കളിലൂടെയും കോറോണ വൈറസ് പകരുമെന്ന് ശാസ്ത്രീയമായി തെളിയിക്കപ്പെട്ടിട്ടില്ല. വൈറസുള്ള ഒരു പ്രതലത്തിലോ വസ്ത ുവിലോ സ്പർശിച്ച ശേഷം ആ കൈ വായിലോ മൂക്കിലോ കണ്ണിലോ തൊട്ടാൽ രോഗം പടരാനിടയുണ്ട്. പക്ഷേ, ഇത് വൈറസ് പടരുന്ന പ് രധാന മാർഗമായി കരുതുന്നില്ല. എന്നിരുന്നാലും വ്യാപനം തടയുന്നതിന് ഭക്ഷ്യവസ്തുക്കൾ പാചകം ചെയ്യുന്നവരും കൈകാര്യ ം ചെയ്യുന്നവരും പ്രത്യേക ശ്രദ്ധ കൊടുക്കേണ്ടതുണ്ട്.
കോവിഡ് പ്രതിരോധത്തിന് ഭക്ഷണസാധനങ്ങളുമായി ബന്ധപ്പ െട്ട് വീടുകളിലും ഭക്ഷണശാലകളിലും ശ്രദ്ധിക്കേണ്ട ചില കാര്യങ്ങൾ ചുവടെ ചേർക്കുന്നു. ഇന്നത്തെ പ്രത്യേക സാഹചര്യത്തിൽ മാത്രമല്ല, എല്ലാ കാലത്തും ഇക്കാര്യങ്ങൾ പ്രസക്തമാണ് എന്നതുകൂടി ഒാർക്കുക.
- കടകളിൽ തിരക്കേറിയ സമയങ്ങളിൽ സാധനങ്ങൾ വാങ്ങാൻ പോകരുത്.
- ക്യൂവിൽ നിൽക്കുമ്പോൾ ആവശ്യത്തിന് അകലം പാലിക്കുക
- ബില്ലടക്കുന്നതിനും മറ്റു പണ ഇടപാടുകൾക്കും പരമാവധി ഗൂഗിൾ പേ, ഫോൺ പേ പോലുള്ളവയോ നെറ്റ് ബാങ്കിങ് സംവിധാനങ്ങളോ ക്രെഡിറ്റ്/ഡെബിറ്റ് കാർഡുകളോ ഉപയോഗിക്കുക
- വീട്ടിലെത്തിയ ശേഷം സാധനങ്ങൾ വാങ്ങിയ കവറുകൾ മാറ്റണം. കൈകൾ സോപ്പിട്ട് കഴുകി വൃത്തിയാക്കണം.
- ഭക്ഷണം കഴിക്കാൻ റസ്റ്ററന്റുകളിൽ/ഹോട്ടലുകളിൽ പോകുന്നത് ഒഴിവാക്കുക.
- പുറത്തുനിന്ന് ഭക്ഷണം അത്യാവശ്യമെങ്കിൽ ആഹാര സാധനങ്ങൾ വാഹനത്തിലേക്ക് വരുത്തുക. ഹോം ഡെലിവറിയും സ്വീകരിക്കാം.

- ഡെലിവറി ഏജന്റുമായി സമ്പർക്കം ഒഴിവാക്കാനായി ഡെലിവറി കോർണർ/ഡെലിവറി ബോക്സ് നല്ലതാണ്.
- ഭക്ഷണം കൈകാര്യം ചെയ്യുന്നതിന് മുമ്പും ശേഷവും ഹാൻഡ് വാഷ്/സോപ്പ് ഉപയോഗിച്ച് കൈ കഴുകണം.
- കത്തി, പാത്രം, കട്ടിങ് ബോഡുകൾ, മേശ എന്നിവ ചൂടുള്ള സോപ്പു വെള്ളം ഉപയോഗിച്ച് കഴുകണം.
- അടുക്കള ടിഷ്യൂ പേപ്പർ/പേപ്പർ ടവ്വൽ ഉപയോഗിച്ച് ഇടയ്ക്കിടെ വൃത്തിയാക്കുക.
- അടുക്കളയിലെയും ഭക്ഷണമുറിയിലെയും ഊൺമേശയും മറ്റും വൃത്തിയാക്കുന്നത് തുണി കൊണ്ടാണെങ്കിൽ അത് തിളയ്ക്കുന്ന വെള്ളത്തിൽ സോപ്പു പൊടിയിട്ട് കഴുകണം.
- പഴങ്ങളും പച്ചക്കറികളും ടാപ്പിനു താഴെ വെച്ച് നന്നായി കഴുകണം.
- കിഴങ്ങുവർഗങ്ങൾ ബ്രഷും വെള്ളവും ഉപയോഗിച്ച് കഴുകുക.
- തുറക്കും മുമ്പേ ടിൻ ഫുഡുകളുടെ അടപ്പ് നന്നായി വൃത്തിയാക്കുക.
- ഭക്ഷണം വിതരണം ചെയ്യുന്നവർ ഡിസ്പോസിബ്ൾ ഗ്ലൗസ് ഉപയോഗിക്കുക.
- ഭക്ഷണം വിളമ്പുന്നവർ ഇടയ്ക്കിടെ ഹാൻഡ് വാഷ് ഉപയോഗിച്ച് കൈ കഴുകണം.

- ഹോട്ടലുകളിൽ ഭക്ഷണം ഉണ്ടാക്കുന്നവരും വിതരണം ചെയ്യുന്നവരും രോഗികളെ സന്ദർശിക്കാൻ പോകരുത്.
- ഭക്ഷണശാലകളിലെ തറ, കസേര, മേശ, വാതിലുകൾ, വാതിൽപ്പിടികൾ, ടോയ്ലറ്റുകൾ എന്നിവ ദിവസം മൂന്ന് തവണയെങ്കിലും വൃത്തിയാക്കണം.
- ഭക്ഷണമേശകൾ തമ്മിലുള്ള അകലം കൂട്ടുക.
- ചുമ, ശ്വാസതടസ്സം എന്നിവയുള്ളവർ ഭക്ഷണം പാചകം ചെയ്യുകയോ വിളമ്പുകയോ ചെയ്യരുത്.
- ഭക്ഷണം പാചകം ചെയ്യുന്നവരും വിളമ്പുന്നവരും മാസ്കും ഹെയർ നെറ്റും ധരിക്കണം.
- കൈ കഴുകുന്ന സ്ഥലത്ത് സോപ്പ്/വെള്ളം ചേർക്കാത്ത ഹാൻഡ് വാഷ് നിർബന്ധമായും ഉണ്ടായിരിക്കണം.
- സോപ്പ്, സാനിറ്റൈസർ, ഹാൻഡ് വാഷ് എന്നിവ നിശ്ചിത ഗുണനിലവാരം ഉള്ളതാണെന്ന് ഉറപ്പുവരുത്തണം. അവ നേർപ്പിച്ചതാകരുത്.
- പല ആളുകൾ സ്പർശിക്കുന്ന ടാപ്പുകൾ സുരക്ഷിതല്ല. അവ ഇടയ്ക്കിടെ വൃത്തിയാക്കണം.
- സെൻസർ ഉള്ള ടാപ്പുകൾ നല്ലതാണ്.
- ഭക്ഷണപദാർഥങ്ങൾ അണുമുക്തമായ സ്ഥലങ്ങളിൽ സൂക്ഷിക്കണം.
- കാഷ് കൗണ്ടറിൽ ഉള്ളവരും ക്ലീനിങ് തൊഴിലാളികളും ഭക്ഷണസാധനങ്ങൾ കൈകാര്യം ചെയ്യരുത്.
- ഇറച്ചി, മുട്ട, പാൽ തുടങ്ങിയവ ആവശ്യമുള്ളത്ര ചൂടിൽ നന്നായി വേവിക്കണം.
- ടോയ്ലറ്റ് ഉപയോഗിക്കുന്നതിനു മുമ്പും ശേഷവും ഹാൻഡ് വാഷ്/സോപ്പ് ഉപയോഗിച്ച് കൈ കഴുകണം.
(കോഴിക്കോട് ഇഖ്റ ഹോസ്പിറ്റൽ കൺസൽട്ടൻറ് ഫിസിഷ്യൻ ആൻഡ് ഡയബറ്റോളജിസ്റ്റ് ആയ ലേഖകൻ ഇന്ത്യൻ മെഡിക്കൽ അസോസിയേഷൻ ഫുഡ് സേഫ്റ്റി ഇനീഷ്യേറ്റീവ് നോർത്ത് സോൺ വൈസ് പ്രസിഡന്റ് കൂടിയാണ്)
Don't miss the exclusive news, Stay updated
Subscribe to our Newsletter
By subscribing you agree to our Terms & Conditions.
